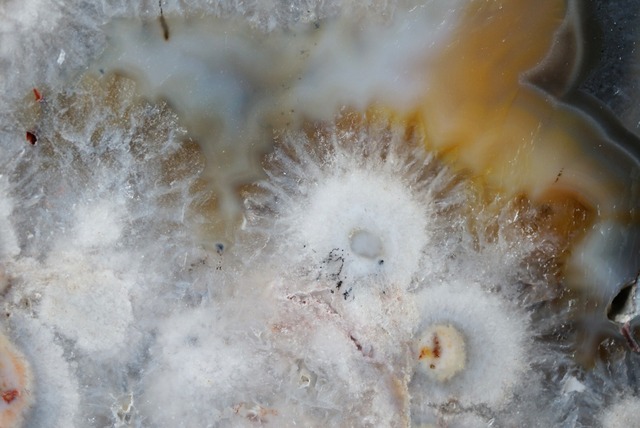
ブラジル産アゲート Agate 1339

ブラジル産アゲート Agate 1339
アゲート Agate
幻想的なブラジル産アゲートスライスです。
放射状に広がった結晶とイエローとブラックのカラーリングが神々しく、絵画的な画面を構成しています。
76x65x10 mm
ブラジル
no1339
ブラジル産アゲート Agate 1339
アゲート Agate
幻想的なブラジル産アゲートスライスです。
放射状に広がった結晶とイエローとブラックのカラーリングが神々しく、絵画的な画面を構成しています。
76x65x10 mm
ブラジル
no1339
¥50税込
SOLD OUT